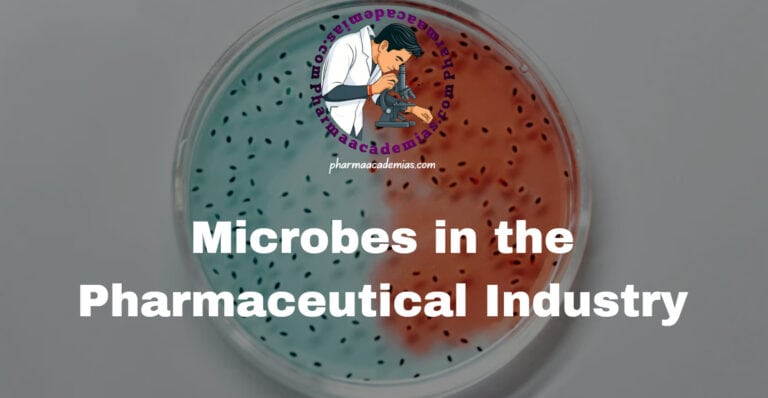
Microbes in pharmaceutical industry

Immunoglobulins (Antibodies) and Their Structure
Introduction to Immunoglobulins Immunoglobulins (Ig), commonly known as antibodies, are glycoprotein molecules produced by B-lymphocytes (B-cells) and plasma cells in response to the presence of antigens. They are essential components of the adaptive immune system, functioning as the humoral arm of immunity. Immunoglobulins are crucial for recognition, neutralization, and elimination of pathogens including bacteria, viruses,…